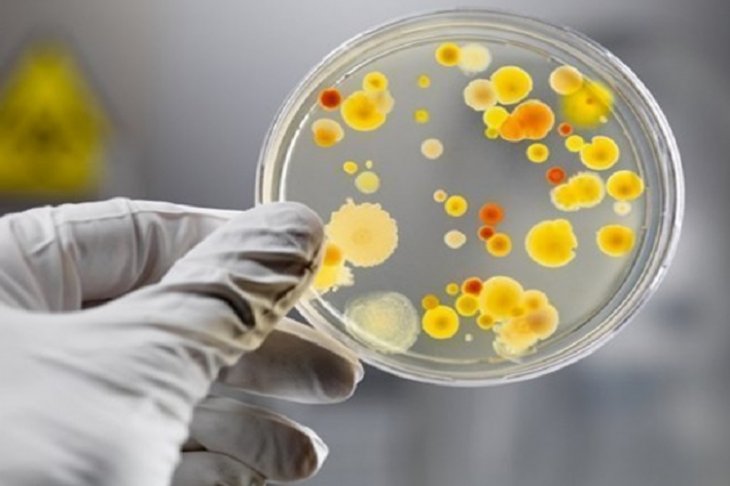

Останні новини
Нероби за гороскопом — четвірка найбільш ледачих знаків ЗодіакуКілька порад, які допоможуть чоловікам покращити спілкування з дружинамиЯкщо зникнуть інтернет, зв'язок, радіо і ТБ: у Львові навчають, як діяти в надзвичайних ситуаціяхНезаконно літав у Крим: на Львівщині прикордонники не пропустили в Україну росіянина"Проводили спалювання під наглядом": в ДСНС прокоментували задимлення в Генконсульстві РФ у ЛьвовіВ екстреному порядку: Австралія закрила посольство у ЛьвовіГенеральне консульство Росії у Львові призупинило роботуТОП-3 знаки Зодіаку, для яких ця весна стане найважчоюЯкий копійчаний компонент додати в шампунь, щоб не мити голову щодняЕстонська розвідка показала карту, на якій Львів позначений ціллю для ймовірного обстрілу з боку російських військУ Львові стався обвал у житловому будинку: люди відмовилися від евакуаціїНідерланди переводять своїх дипломатів з Києва до Львова«Обманом змусили дути в драгер»: депутата зі Львівщини 4 рази впіймали п'яним за кермом67-річна жінка 3 місяці ходила зі зламаним хребтом і навіть не підозрювала про цеМеновазин: особливості застосування та ефективність препарату*Львівські бабаки дали свої прогнози на прихід весниУ Львові лікар протягнув зубами швидку, щоб привернути увагу до щеплення проти поліомієліту: відеоЯк знаки зодіаку створюють собі проблеми і псують життя — це допоможе зрозуміти корінь ваших проблемУ якому напрямку біжить людина? Тест покаже,як ви думаєте – чоловік або як жінкаБританія вслід за США переводить своїх дипломатів до Львова«Евакуація» до Львова: місцева влада розповіла, чи просили іноземні посольства виділити їм приміщення
Авторизація
Календар публікацій
| « Березень 2026 » | ||||||
|---|---|---|---|---|---|---|
| Пн | Вт | Ср | Чт | Пт | Сб | Нд |
| 1 | ||||||
| 2 | 3 | 4 | 5 | 6 | 7 | 8 |
| 9 | 10 | 11 | 12 | 13 | 14 | 15 |
| 16 | 17 | 18 | 19 | 20 | 21 | 22 |
| 23 | 24 | 25 | 26 | 27 | 28 | 29 |
| 30 | 31 | |||||
15 січ 14:21Новини Львів / Ситуації
54-річний львів'янин помер від важкої форми лептоспірозу
У новому році на Львівщині зафіксовано вже два випадки лептоспірозу, один з них – летальний. Помер 54-річний львів’янин, в якого діагностували важку форму лептоспірозу.
Про це повідомила завідувачка відділу особливо небезпечних інфекцій львівського обласного лабораторного центру Ірина Куліш.
«54-річного львів’янина госпіталізували до Львівської обласної клінічної лікарні 9 січня у дуже важкому стані. Лабораторні дослідження показали, що у нього важка форма лептоспірозу, джерелом інфекції є щурі. Лікарі боролися за його життя, але врятувати чоловіка не вдалося і 11 січня він помер», - повідомила Ірина Куліш.
У розмові з сином лікарям вдалося встановити, що у підвалі будинку, де мешкав батько, було багато щурів. Він навіть звертався у відповідні служби, аби знешкодили їх. Чоловік напередодні прибирав у підвалі і, наймовірніше, через невеликі подряпини лептоспіри (збудники хвороби) потрапили в кров.
Нездужання, як повідомила Ірина Куліш, почалося ще 3 січня. Симптоми були такі, як при ГРВІ: підвищення температури, слабкість, ломота в тілі. Чоловік звертався до сімейного лікаря, викликав «швидку» і лише 9 січня потрапив до лікарні, де йому встановили діагноз – лептоспіроз.
Другий випадок лептоспірозу зафіксовано 11 січня у Жидачівському районі. До інфекційного відділення Жидачівської центральної районної лікарні госпіталізували 57-річного чоловіка з села Подорожнє. Його стан – середньої важкості.
Торік на Львівщині було зафіксовано 24 випадки лептоспірозу, три з них – летальні.
Нагадаємо, лептоспіроз - це гостре інфекційне захворювання людей і тварин, яке спричиняється збудником лептоспірою, і характеризується ураженням печінки, нирок, м'язів і супроводжується хвилеподібною гарячкою.
З моменту зараження до початку хвороби проходить від 6 до 20 днів. Захворювання у більшості випадків починається гостро, підвищується температура тіла до 39-40 С, хворі скаржаться на сильний головний біль, слабість, біль в м’язах, особливо литкових.
Основними носіями збудника лептоспірозу у природних умовах є щурі, польові миші, землерийки, їжаки.
Читайте також:
На Львівщині від лептоспірозу помер 45-річний чоловікУ лікарні померла 68-річна жінка, у якої діагностували сказУ жовтні у трьох мещканців Львівщини діагностували лептоспірозАтака кліщів: на Львівщині хворобу Лайма виявили у 17 людей3-річна дівчинка померла від менінгококової інфекції на Львівщині. Лікарі тиждень мовчали про інцидент
Додати коментар
КАРТИНА ДНЯ
Новини партнерів
Відео матеріали
Ми у соцмережах